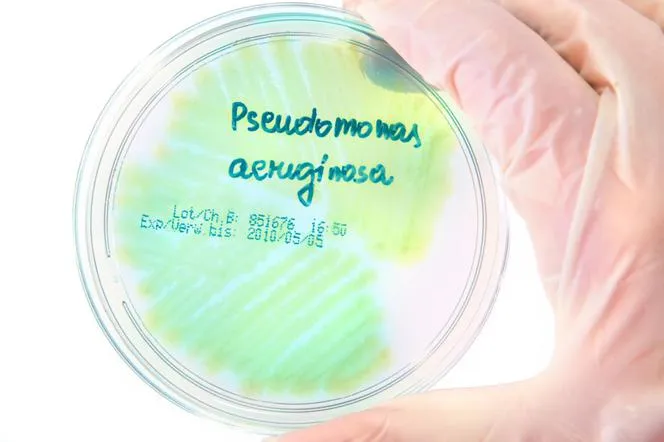
Pseudomonas aeruginosa w moczu: Co oznacza dla Twojego zdrowia?

Odkryj najlepsze probiotyki na jelita! Porównujemy top 3 produkty, analizujemy składniki i doradzamy, jak wybrać odpowiedni suplement dla Twojego zdrowia. Sprawdź, który probiotyk najlepiej zadba o Twoje jelita!
Jestem założycielem i głównym autorem portalu o zdrowiu, który powstał z mojej pasji do medycyny i zdrowego stylu życia. Jako wykwalifikowany dietetyk z wieloletnim doświadczeniem, postanowiłem dzielić się wiedzą, która pomaga ludziom żyć pełniej i zdrowiej. Moja misja to dostarczanie rzetelnych, opartych na badaniach informacji o żywieniu, fitnessie i zdrowiu psychicznym. Wierzę, że każdy ma prawo do dostępu do wiedzy, która może znacząco poprawić jakość życia. Dążę do tego, by mój portal był miejscem, gdzie czytelnicy znajdą praktyczne porady, inspiracje oraz wsparcie w dążeniu do lepszego zdrowia.

Odkryj najlepsze probiotyki na jelita! Porównujemy top 3 produkty, analizujemy składniki i doradzamy, jak wybrać odpowiedni suplement dla Twojego zdrowia. Sprawdź, który probiotyk najlepiej zadba o Twoje jelita!
Dowiedz się, co oznacza obecność Pseudomonas aeruginosa w moczu dla Twojego zdrowia. Poznaj objawy, diagnostykę, leczenie i profilaktykę tej groźnej bakterii. Zadbaj o swój układ moczowy już dziś!

Poznaj 7 najczęstszych objawów problemów z jelitami i skuteczne metody leczenia. Dowiedz się, jak rozpoznać niepokojące sygnały i jakie kroki podjąć, aby poprawić zdrowie układu pokarmowego.

Dowiedz się, jakie powikłania po antybiotyku mogą Ci zagrażać i jak skutecznie im zapobiegać. Poznaj objawy, metody diagnostyki i sposoby ochrony przed niepożądanymi efektami antybiotykoterapii.

objawy, diagnostykę i skuteczne leczenie. Dowiedz się, jak rozpoznać infekcję, jakie badania wykonać i jak chronić się przed zarażeniem. Zdrowie jelitowe w Twoich rękach!

Odkryj najskuteczniejsze probiotyki ginekologiczne! Porównaj doustne i dopochwowe preparaty, poznaj ich działanie i wybierz najlepszy dla siebie. Sprawdź nasz ranking i zadbaj o zdrowie intymne.

Odkryj, jak rozpoznać pasożyty w oczach i chronić swój wzrok. Poznaj objawy, metody diagnostyki i leczenia tych niewidocznych, ale groźnych intruzów. Działaj, zanim będzie za późno!

Odkryj wpływ filmowych diet na nasze nawyki żywieniowe. Analizujemy popularne trendy, ich skutki zdrowotne oraz etyczne aspekty przedstawiania żywienia w kinie.

Odkryj, jak rozpoznać pasożyty w kale i skutecznie je zwalczyć. Dowiedz się, jakie objawy mogą wskazywać na infekcję, szczególnie u dzieci. Poznaj metody diagnostyki i leczenia dla zdrowia całej rodziny.

Poznaj 5 alarmujących zmian skórnych wskazujących na pasożyty. Dowiedz się, jak rozpoznać pasożyty objawy skórne u siebie i dzieci. Skuteczna diagnoza i leczenie krok po kroku.